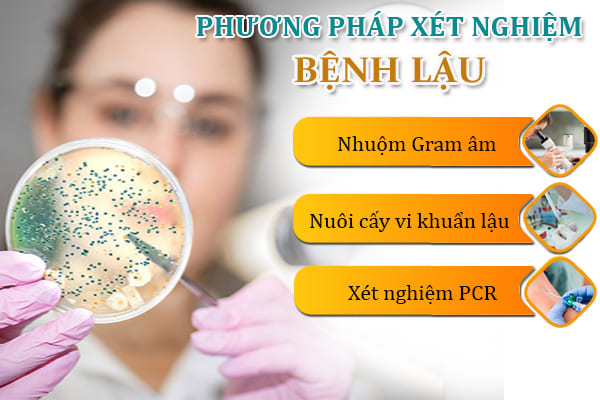

Triệu chứng bệnh giang mai như thế nào luôn là thắc mắc của nhiều người bệnh khi không thể tự mình nhận biết được những dấu hiệu bệnh giang mai. Có những trường hợp bệnh giang mai biểu hiện rõ dấu hiệu nhưng cũng có những trường hợp bệnh không có biểu hiện rõ ràng. Vậy có thể nhận biết biểu hiện bệnh giang mai như thế nào? Cùng các bác sĩ tại Đa khoa Quốc Tế Việt Sing tìm hiểu về bài viết sau đây.
1. Thế nào là bệnh giang mai?

Vi khuẩn Treponema pallidum gây bệnh giang mai lây truyền qua đường tình dục. Vi khuẩn xâm nhập vào cơ thể thông qua các vết thương và vết trầy xước trên da. Mặc dù phần lớn bệnh lây truyền qua đường tình dục, nhưng cũng có thể lây truyền từ mẹ sang con.
Giang mai lây qua đường tình dục với những triệu chứng bệnh giang mai. Hiện nay, đây cũng là một căn bệnh xã hội khá phổ biến, nhưng hầu hết mọi người không biết nhiều về nó. Bệnh giang mai, bệnh lậu và HIV là ba loại bệnh lây truyền qua đường tình dục gây ra nhiều hậu quả cho cả người mắc bệnh và xã hội.
>>> Xem thêm bài viết khác
- Tìm hiểu chung: Giang mai là bệnh gì? Triệu chứng, nguyên nhân, chẩn đoán bệnh
- Bác sĩ chuyên khoa giải đáp: Bệnh giang mai có chữa được không?
2. Nguyên nhân gây nên bệnh giang mai là gì?

Theo các bác sĩ tại phòng khám Đa khoa Quốc tế Việt Sing, vi khuẩn Treponema pallidum là nguyên nhân gây bệnh giang mai. Năm 1905, loại vi khuẩn này được tìm thấy và có hình dạng giống lò xo với 6–14 vòng xoắn. Không thể sống sót trong cơ thể người trong nhiều giờ do sức đề kháng yếu của Treponema pallidum. Nhiệt độ phù hợp với sự phát triển của xoắn khuẩn là 37 độ C. Xoắn khuẩn có thể bị sát khuẩn và xà phòng diệt trong vài phút.
Việc tiếp xúc trực tiếp với người bệnh thông qua quan hệ tình dục đường âm đạo, đường hậu môn hoặc đường miệng, bệnh sẽ lây lan. Bệnh cũng có thể lây truyền gián tiếp qua vật dụng, đồ dùng hoặc vết xước trên da hoặc niêm mạc. Ngoài ra, bệnh có thể lây truyền qua đường máu hoặc từ mẹ sang con khi mang thai với các biểu hiện bệnh giang mai điển hình.
Bệnh giang mai sẽ không tái phát sau khi chữa khỏi. Tuy nhiên, tiếp xúc với vết loét giang mai của một người khác có thể khiến bạn tái nhiễm. Đặc biệt, các triệu chứng bệnh giang mai ( bệnh xã hội ) có thể lây nhiễm qua nhiều đường khác nhau như đường tình dục, lây qua máu, lây từ mẹ sang con, lây nhiễm gián tiếp do dùng chung đồ cá nhân. Do đó, người bệnh hãy cẩn thận hơn trong việc sinh hoạt hàng ngày.
3. Giải đáp: Nhận biết triệu chứng bệnh giang mai qua từng giai đoạn

Như đã nói ở trên, từng giai đoạn bệnh giang mai khác nhau sẽ biểu hiện những dấu hiệu bệnh giang mai khác nhau. Từng giai đoạn bệnh giang mai sẽ được chia ra thành từng cấp độ như sau:
Triệu chứng bệnh giai đoạn 1
Đây là giai đoạn đầu khi bệnh giang mai mới chớm nên có thể thấy những triệu chứng bệnh giang mai vẫn tương đối nhe:
- Tổn thương xuất hiện trong khoảng ba đến bốn tuần sau khi lây bệnh.
- Có vết trợt nông không có gờ nổi lên trên da, có hình tròn hoặc bầu dục, nền cứng và màu đỏ tươi.
- Tổn thương chủ yếu xảy ra ở niêm mạc sinh dục. Nữ giới thường bị tổn thương ở mép âm hộ, môi bé và môi lớn. Nam giới thường bị tổn thương ở dương vật, bìu, miệng sáo, quy đầu và các vùng khác.
- Hạch xuất hiện ở vùng bẹn có hình dạng sưng to, thành chùm và hạch to nhất được gọi là hạch chúa.
Triệu chứng bệnh giai đoạn 2
Đến giai đoạn này, bệnh đã phát triển nặng hơn, những biểu hiện bệnh cũng rõ ràng và trở nặng hơn, điển hình như các biểu hiện bệnh giang mai sau:
- Bệnh giang mai giai đoạn này được tính từ khi có các dấu hiệu bệnh và kéo dài khoảng 6 – 8 tuần.
- Các dát đỏ hồng phủ khắp thân mình với nhiều hình dạng khác nhau, chẳng hạn như sẩn đỏ hồng có vảy xung quanh, sẩn dạng vảy nến, sẩn hoại tử.
- Vùng da bị viêm hạch lan rộng.
Triệu chứng bệnh giai đoạn 3
Đây chính là giai đoạn bệnh đã chuyển nặng trong các triệu chứng bệnh giang mai mà người bệnh có thể thấy rõ ràng những triệu chứng đã trở nặng và xuất hiện nhiều biến chứng nguy hiểm khác. Điển hình cho các dấu hiệu bệnh giang mai giai đoạn 3 là:
- Các nốt sần đỏ xuất hiện nhiều khắp người, gây tổn thương nhiều vùng cơ thể
- Sốt cao, mệt mỏi, đau đầu
- Đau nhức xương khớp, tổn hại tim mạch, thần kinh
Triệu chứng bệnh giai đoạn 4
Đây là giai đoạn bệnh giang mai vô cùng nguy hiểm. Đến thời điểm này, nhiều cơ quan trên cơ thể có thể bị ảnh hưởng, chẳng hạn như tim, tế bào máu, não và hệ thần kinh. Bệnh sẽ gây tổn thương các cơ quan và có thể gây tử vong và phá hủy hệ thống thần kinh ở giai đoạn này.
Các bác sĩ gọi điều này là giang mai bẩm sinh. Thai nhi không được điều trị có nguy cơ cao bị chết lưu và trẻ sinh ra có nguy cơ cao tử vong.
Phần lớn trẻ em mắc bệnh sẽ có các triệu chứng bệnh giang mai không có bất kỳ triệu chứng nào. Một số có thể gây phát ban ở lòng bàn chân hoặc bàn tay. Các biểu hiện sau đây thường xuất hiện ở trẻ sơ sinh bị giang mai:
- Gan to bất thường
- Vàng da, xương bất thường
- Ảnh hưởng đến não
Giai đoạn giang mai thần kinh và mắt
Bệnh nhân giang mai thần kinh và thị giác xuất phát từ chính các biểu hiện hay vấn đề về thị lực vì tình trạng này chỉ xuất hiện sau nhiều năm không được điều trị. Đây được coi là giai đoạn biến chứng, giai đoạn cuối của bệnh đặc biệt nguy hiểm của bệnh giang mai. Một số biểu hiện bệnh giang mai điển hình trong giai đoạn này như:
- Đau cơ, đau khớp và đau chân tay
- Đau đầu đáng kể
- Đi bộ không chắc chắn
- Điều khó khăn là phối hợp các chuyển động cơ bắp
- Tiểu không có sự kiểm soát;
- Co giật và sự tê liệt của các chi
- Thất thường tâm lý, thay đổi tính cách và sai lầm trong quyết định
- Hoang tưởng và trí nhớ suy giảm
Với những triệu chứng bệnh giang mai, có thể thấy bệnh tương đối nguy hiểm, ảnh hưởng trực tiếp tới sức khỏe, tính mạng của người bệnh nếu như không điều trị ở giai đoạn sớm. Lời khuyên dành cho bạn chính là khi nhận thấy những biểu hiện bất thường ở cơ thể nên đi thăm khám để có thể biết chính xác bệnh, nhận biết nhanh những dấu hiệu bệnh giang mai và kịp thời điều trị bệnh.
4. Biện pháp phòng ngừa bệnh giang mai hiệu quả là gì?

Bởi vì bệnh giang mai có thể xảy ra ở bất kỳ ai, bạn cần đến ngay bệnh viện hoặc phòng khám để được tiến hành xét nghiệm chẩn đoán và điều trị khỏi. Tuy nhiên, người bệnh không nên chủ quan; họ cần tuân thủ đúng chỉ định và hướng dẫn của bác sĩ để điều trị hiệu quả nhất có thể. Nếu không được chữa trị đúng cách, bệnh giang mai có thể tiến triển và gây ra các biến chứng nguy hiểm.
Ngăn ngừa sự tấn công của vi khuẩn là phương pháp phòng ngừa các triệu chứng bệnh giang mai hiệu quả.
Bạn có thể ngăn ngừa bệnh giang mai bằng những cách sau đây
- Sử dụng bao cao su để có quan hệ tình dục an toàn với bạn tình.
- Không có quan hệ tình dục với nhiều người và sống chung thủy với tư cách là một vợ một chồng.
- Giai đoạn đầu của bệnh giang mai rất dễ bỏ qua vì triệu chứng không khó chịu và có thể tự khỏi sau ba đến sáu tuần. Do đó, bạn nên đi khám bác sĩ 6 tháng một lần để phát hiện bệnh sớm và điều trị nó sớm.
- Tránh tiếp xúc vô tình với dịch tiết của người bị bệnh bằng cách sử dụng chung các vật dụng cá nhân như bàn chải đánh răng, khăn tắm và đồ lót.
- Để giảm tỷ lệ lây nhiễm, phụ nữ mang thai cần tuân thủ chỉ định của bác sĩ về chăm sóc thai kỳ và sinh con.
Ngoài ra, việc chủ động thăm khám và điều trị bệnh là vô cùng quan trọng, thời điểm lý tưởng để điều trị bệnh chính là nhận biết sớm bệnh và nhanh chóng điều trị, hạn chế những ảnh hưởng do bệnh gây ra. Bạn có thể đến với địa chỉ Phòng khám Đa khoa Quốc Tế Việt Sing để được thăm khám chuyên khoa và nghe tư vấn của bác sĩ để có hướng điều trị bệnh phù hợp.
Trên đây là những thông tin quan trọng về các triệu chứng bệnh giang mai mà bạn không thể bỏ lỡ bởi đây là những dấu hiệu giúp bạn nhận biết sớm giai đoạn đầu của bệnh và điều trị hiệu quả. Trường hợp bạn có thắc mắc cần giải đáp, hãy liên hệ đến số hotline 0222 730 2022 để được tư vấn nhanh chóng, chính xác nhé.
✯ Tư vấn 24/24
- Tư vấn trực tuyến: Click tại đây
- Liên hệ Hotline: 0222.730.2022
✯ Hy vọng những thông tin mà chúng tôi chia sẻ trên sẽ giúp ích đến các bạn. Cảm ơn các bạn đã đọc và theo dõi bài viết.












![[Tìm hiểu] Chi phí chữa mụn rộp Bắc Ninh giá bao nhiêu? Có đắt không?](https://phongkhambacninh.com/wp-content/uploads/2025/10/chi-phi.jpg)